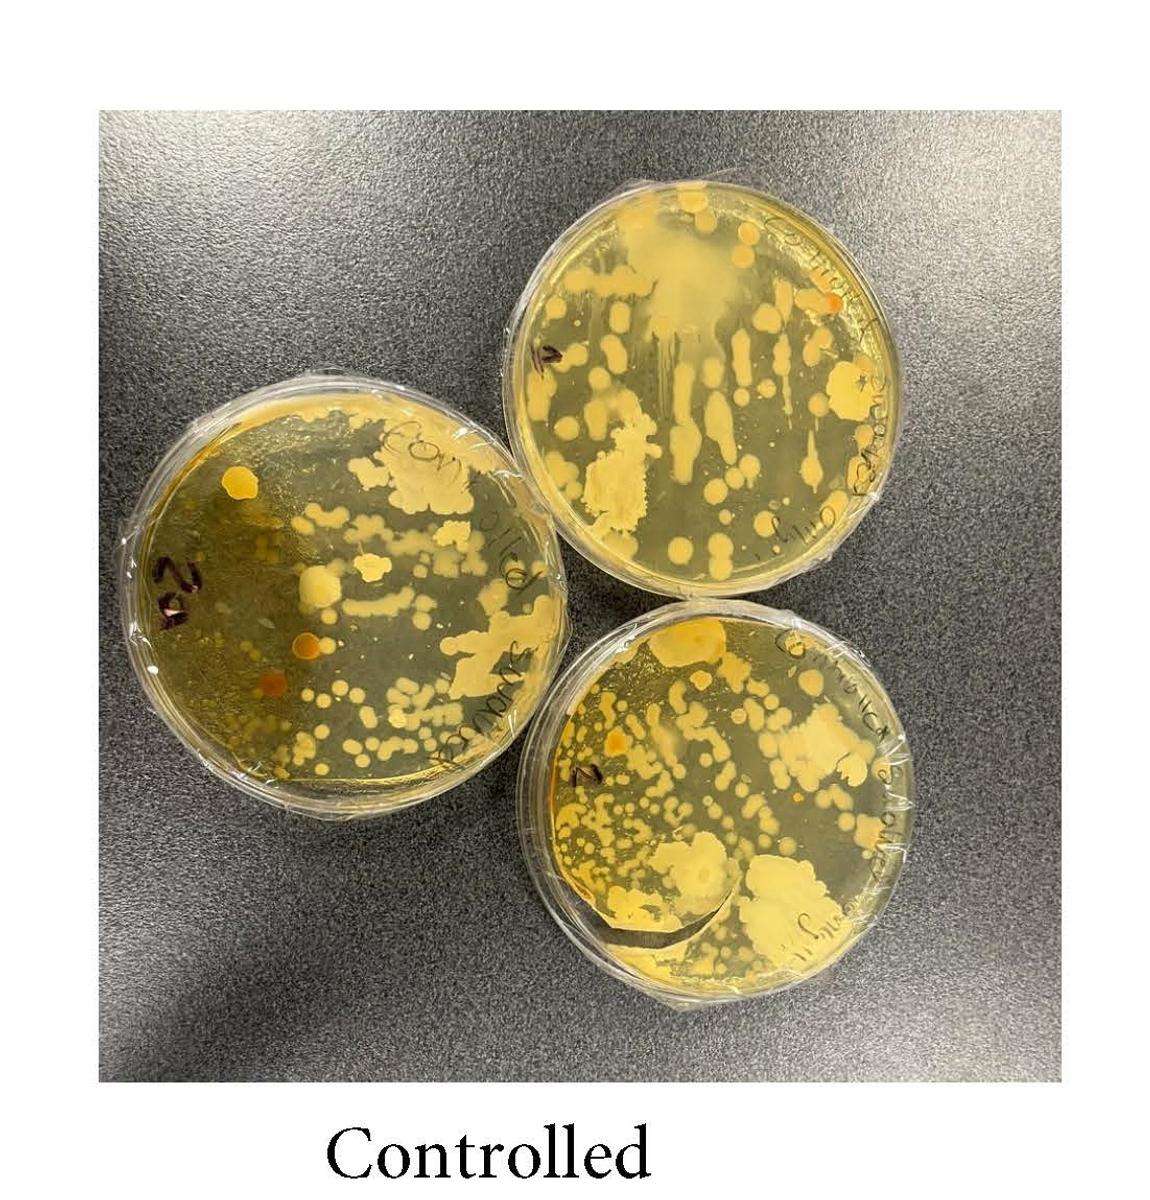
Gallery Image
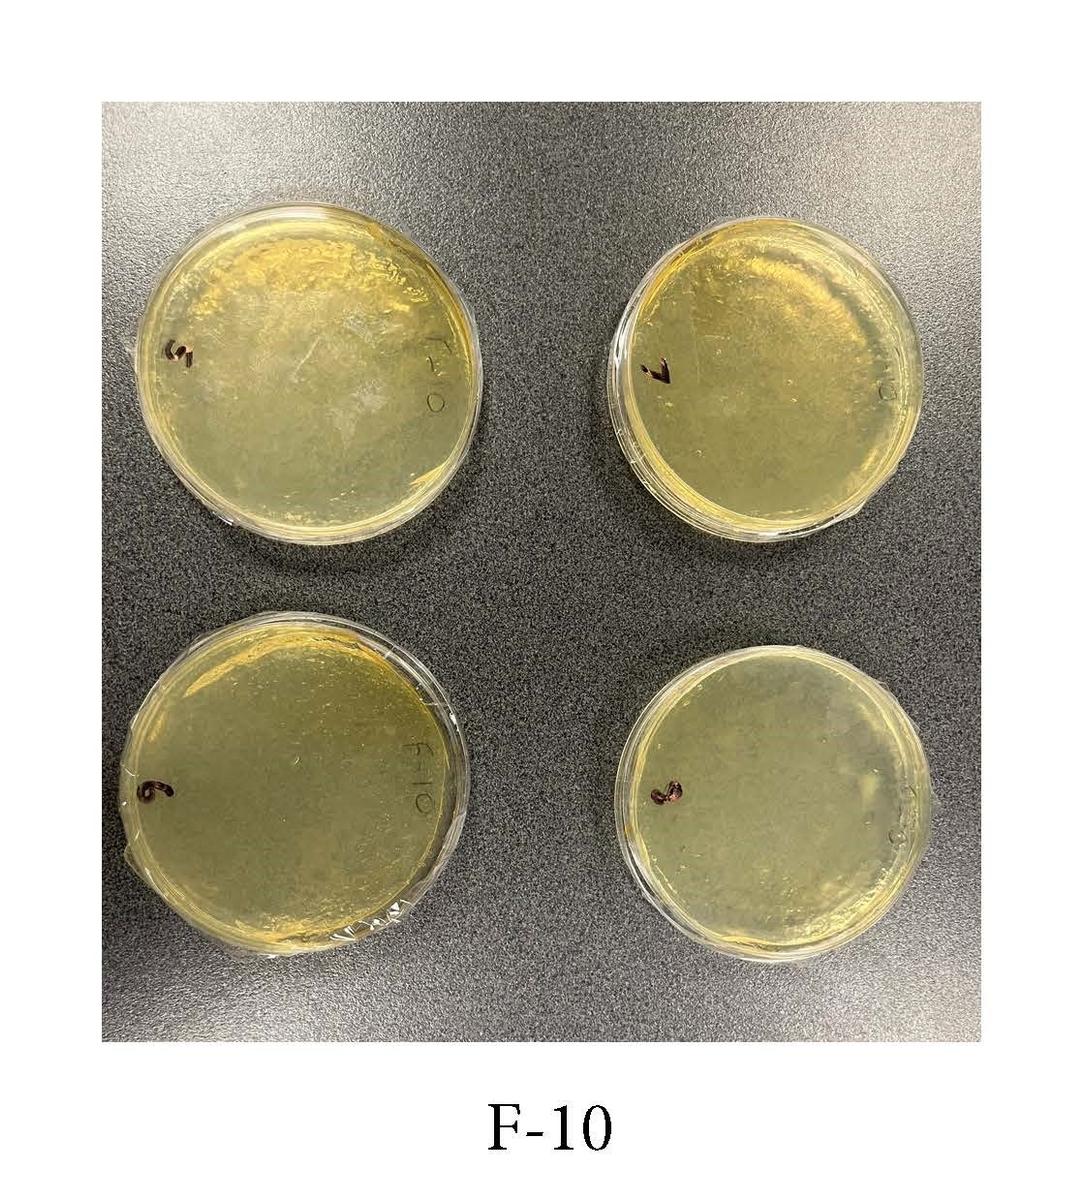
Gallery Image
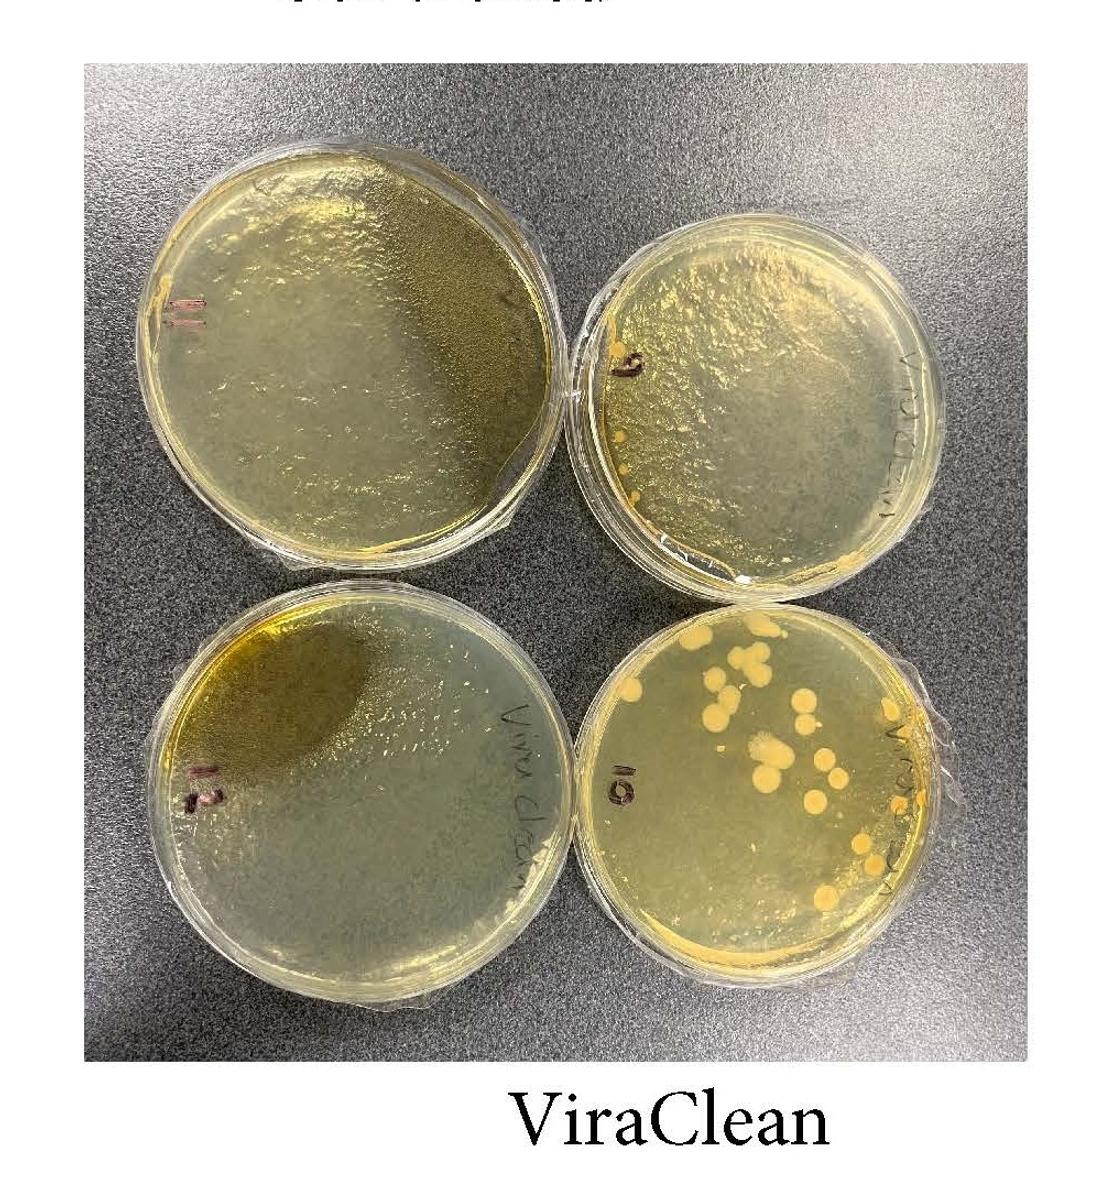
Gallery Image
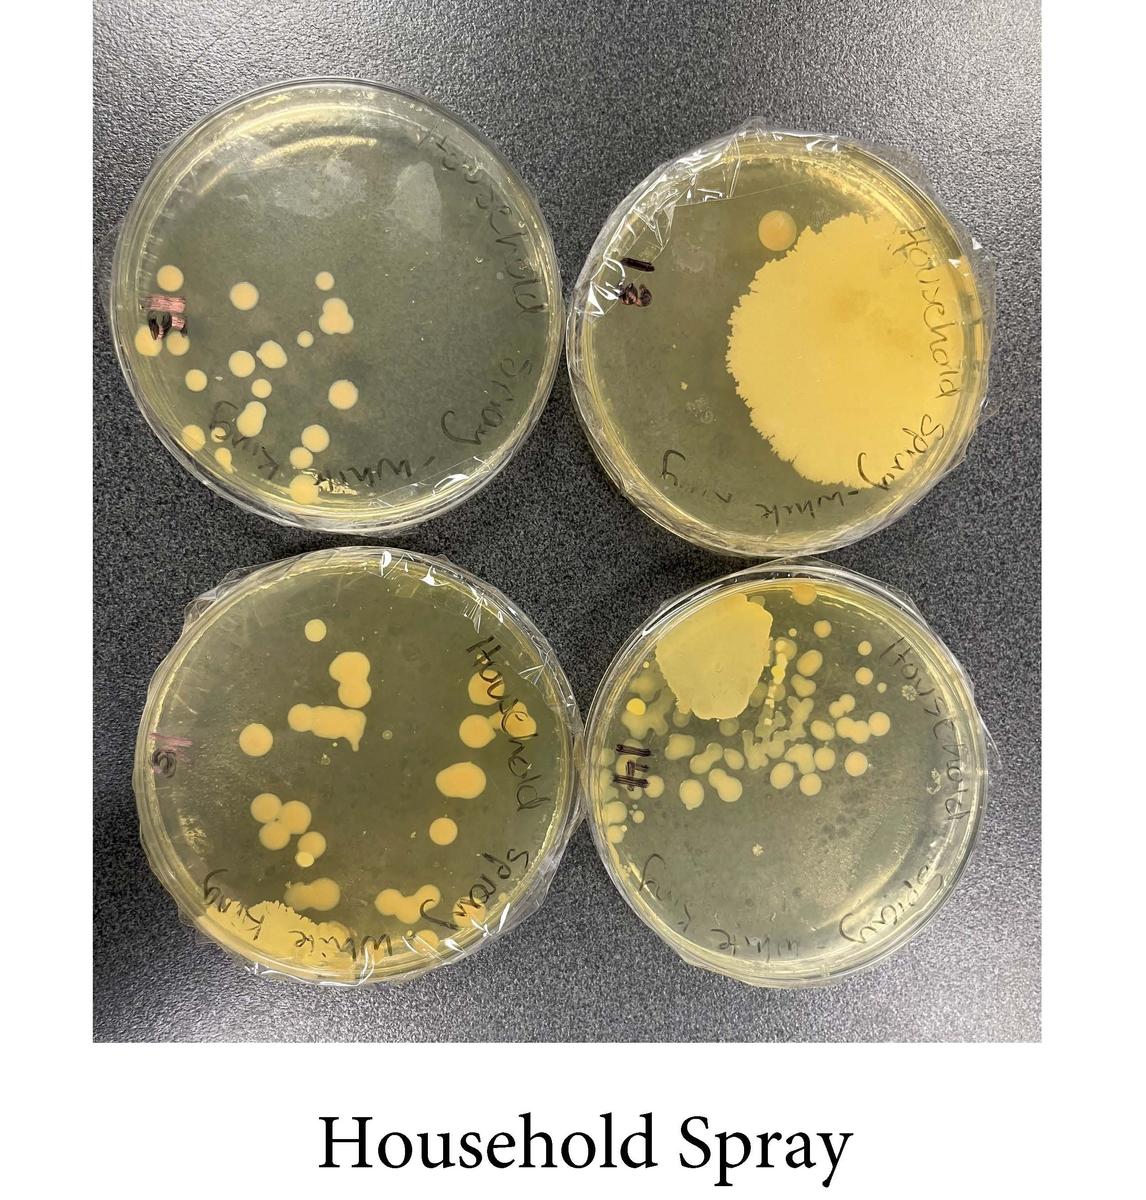
Gallery Image

Cleaning Agents Vs Bacteria

BSC student, Emilie Falzon, recently completed a science experiment about the effectiveness of cleaning agents on bacteria, with some surprising results.
| Plates: | Conditions | Results: | Average: | ||||||
| Controlled Swabbed only: | |||||||||
| 1 | 50.00% | 63.30% | |||||||
| 2 | 80% | ||||||||
| 2a | 60% | ||||||||
| F-10: | |||||||||
| 3 | 0% | 0% | |||||||
| 4 | 0% | ||||||||
| 5 | 0% | ||||||||
| 6 | 0% | ||||||||
| Viraclean: | |||||||||
| 7 | 0.00% | 6.75% | |||||||
| 8 | 0% | ||||||||
| 9 | 2% | ||||||||
| 10 | 25% | ||||||||
| White King: | |||||||||
| 11 | 50.00% | 36.75% | |||||||
| 12 | 35% | ||||||||
| 13 | 37% | ||||||||
| 14 | 25% | ||||||||